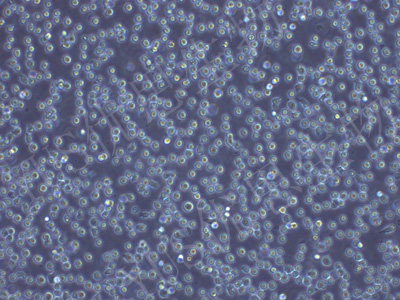

产品中心
产品中心
-
DT40 鸡淋巴瘤细胞
货号:YLE025规格: 1*10^6 -

LMH 鸡肝癌细胞(种属鉴定)
货号:YLE026规格: 1*10^6 -

F81 猫肾细胞(种属鉴定)
货号:YLE027规格: 1*10^6 -

OAR-L1 绵羊肺成纤维细胞(种属鉴定)
货号:YLE028规格: 1*10^6 -

MDBK NBL-1 牛肾细胞(种属鉴定)
货号:YLE029规格: 1*10^6 -

CCC-SMC-1 兔主动脉平滑肌细胞
货号:YLE030规格: 1*10^6 -

C6/36 幼蚊细胞
货号:YLE041规格: 1*10^6 -

Sf21 昆虫卵巢细胞(种属鉴定)
货号:YLE042规格: 1*10^6 -

Sf9 昆虫卵巢细胞(种属鉴定)
货号:YLE043规格: 1*10^6
在线咨询
Online consultation

关注微信公众号


